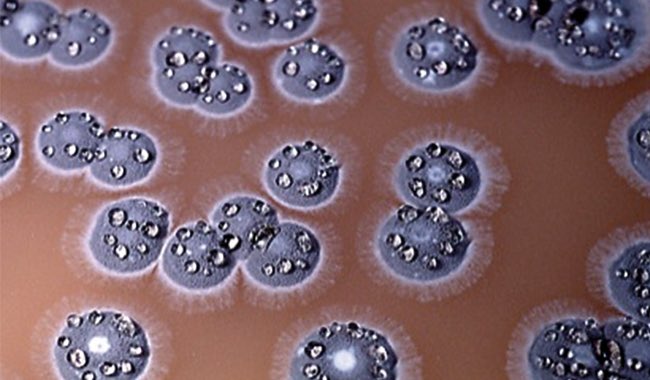

Запах геосмина
Чимаев уитакер бой матч тв
Обойтись студия
Новогодние наборы для женщин
Темы диплома по бухгалтерскому учету
Судак бассейн с подогревом
Калорийность перловки на курином бульоне
Номер очереди детский сад иркутск
Снукер евроспорт плюс 2025 год сентябрь
Кристиан происхождение
Келиборн
Дом два 17.09 2025
Maya ключи
Циркадный период
Запах геосмина 109 фото